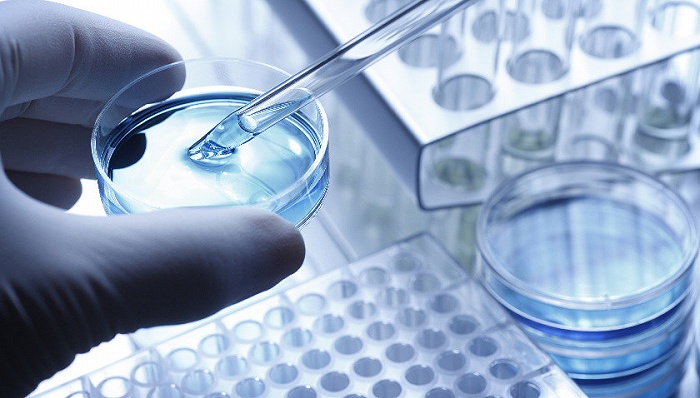

原标题:与昔日大客户对簿公堂的合富中国,为何屡改上市计划?

实习记者 | 杜尚哲
近期,合富(中国)医疗科技股份有限公司(下称合富中国)向上交所递交了IPO招股书,海通证券为其保荐人。合富中国计划首发9951.32万股,预计融资超6.6亿元。
据悉,合富中国从属于体外诊断产品的流通与服务行业,主营体外诊断产品集约化业务和医疗产品流通两大业务。
合富中国为各地医疗机构提供体外诊断仪器与体外诊断试剂、耗材、维修零配件的一体化流通服务,减少原厂与医疗机构之间的代理层级,为医院节省试剂耗材采购成本。

近四年,合富中国营业收入不断增长,2020年上半年营业收入超5亿元,净利润接近3500万元。

当前无实际控制人
2019年1月,合富有限整体变更为外商投资股份有限公司,股份制改造后名称变更为合富中国,此后,合富中国共经历多次股权变动。
公司发起时,合富(香港)控股有限公司持有合富中国超2亿股,持股比例达96.19%。2019年5月,25名增资方增资后,联方有限公司(联方有限)和国泰创业投资股份有限公司(国泰创业)分别持股合富中国1.89%和1.53%。数日后,新股东嘉兴海通旭初股权投资基金合伙企业(嘉兴海通)以1,250万新增股份持股4.83%成为第二大股东。
2019年6月增资时,荆州慧康股权投资基金合伙企业(荆州慧康)认购2,500万股,取代原来嘉兴海通的位置。数月后,合富中国再次增资,大股东合富香港持股比例下降至73.34%。2019年12月,第二大股东荆州慧康转让其持有部分股份给宁波梅山保税港区祺睿股权投资中心(祺睿投资)。2020年7月和10月,合富中国的股东再次进行了两次股权转让,当前,持股比例前三的股东分别是合富香港,荆州慧康和嘉兴海通。

招股书提到,合富中国的间接控股股东合富医疗控股股份有限公司为台湾证券交易所上市企业,股权结构分散。报告期内,合富控股大股东李惇夫妇及子女始终持有合富控股最多的股份且无法对合富控股股东会及董事会形成有效控制,因此合富控股无实际控制人导致合富中国无实际控制人。
经营现金流持续为负
2017年至2020年上半年,合富中国主营业务收入虽增长,但经营活动现金流量净额持续为负,分别为2,463.46万元、-7,670.67万元、-3,789.10万元及-5,422.00万元。2020年1-6月,合富中国投资规模有所缩减,投资活动产生的现金流量净额回正。依靠投资活动的现金回流,2020年上半年现金净增加额创新高,接近5500万元。
2017年,2018年,2019年的2020年1-6月,合富中国应收账款余额分别为31,313.84万元、37,496.31万元、54,297.09万元和64,308.37万元,总体增长幅度较大,占营业收入的比例分别为46.05%、41.46%、51.86%和63.62%。

与昔日大客户对簿公堂
2019年12月12日和2020年11月3日,合富中国两次以佑安医院拖欠货款为由向上海市徐汇区人民法院提起诉讼,诉讼涉及近3500万应付货款及近千万违约金,目前均未有结果。
值得注意的是,2017年和2018年,佑安医院曾连续两年成为合富中国的第一大客户,2019年也以7387.15万元的采购金额排名第二。
2020年上半年,合富中国的应收账款余额坏账准备由上年末的964.16万元增长至1436.73万元,招股书中也专门提到,合富中国已根据坏账计提政策对这部分应收账款充分计提坏账准备。

19年来两次更改上市计划
记者通过调查发现,早在2019年7月,合富中国就已经在华泰证券的辅导下开启IPO征程,拟于上交所上市。2020年8月,在因“公司整体发展战略调整”而终止辅导数日后,海通证券成为新的保荐人,协助合富中国冲击创业板。
3个月后的2020年11月,海通证券在辅导工作进度报告中报告了合富中国“基于未来发展战略”,将拟上市板块变更为沪市主板。数次更改上市计划,合富中国究竟有何打算?